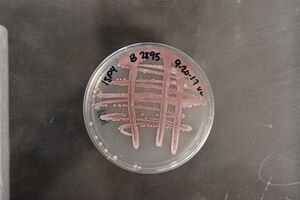

Streptomyces puniceus الإنجليزية (Q2089285)
species of Actinobacteria الإنجليزية
| اللغة | التسمية | الوصف | أسماء أخرى |
|---|---|---|---|
| العربية | لم تُضف التسمية |
لا يوجد وصف |
|
| الإنجليزية | Streptomyces puniceus |
species of Actinobacteria |
بيانات
Wikidata item الإنجليزية
taxon name الإنجليزية
taxon rank الإنجليزية
parent taxon الإنجليزية
instance of الإنجليزية
Gram staining الإنجليزية
LPSN URL الإنجليزية
Google Knowledge Graph ID الإنجليزية
image الإنجليزية
Streptomyces puniceus subspecies puniceus NRRL B-2895 (Type Strain).jpg
١٬١٥٢ × ٧٦٨؛ ١٧٥ كيلوبايت
١٬١٥٢ × ٧٦٨؛ ١٧٥ كيلوبايت
١ مراجع
Imported from Wikidata item الإنجليزية